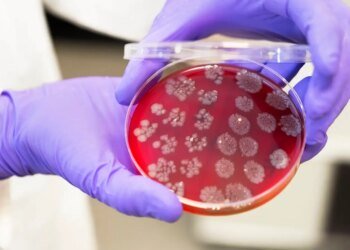

A National Institute on Ageing survey reveals social isolation, financial stress, and a steep decline in positive feelings toward ageing among older Canadian adults.
Medscape News Canada
Source link : https://www.medscape.com/viewarticle/optimism-about-ageing-plummets-among-older-canadians-2026a10002ul?src=rss
Author :
Publish date : 2026-01-29 10:20:00
Copyright for syndicated content belongs to the linked Source.